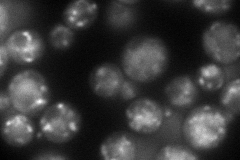
YDR107C
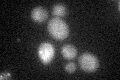
YDR107C

View description
Protein with a role in cellular adhesion and filamentous growth; similar to Emp70p and Tmn3p; member of the evolutionarily conserved Transmembrane Nine family of proteins with nine membrane-spanning segments
Localization:
Intensity:
Fold change:
Significance:
-
C’ GFP library in SD

below threshold17.3 -
N' NOP1pr-GFP in SD
punctate91.7515 -
N' TEF2pr-mCherry in SD

vacuole72.1607 -
N' NATIVEpr-GFP in SD

punctate22.5689 -
N' TEF2pr-VC and Cyto-VN in SD

#N/A0 -
C’ GFP library in SD+DTT
cytosol14.080.81No -
C’ GFP library in SD+H2O2

cytosol16.390.94No -
C’ GFP library in Starvation Media

cytosol160.92No -
C’ GFP library on the background of Pup2-DaMP

below threshold -
C’ GFP library on the background of CCT mutant

below threshold15.54510.898114No
